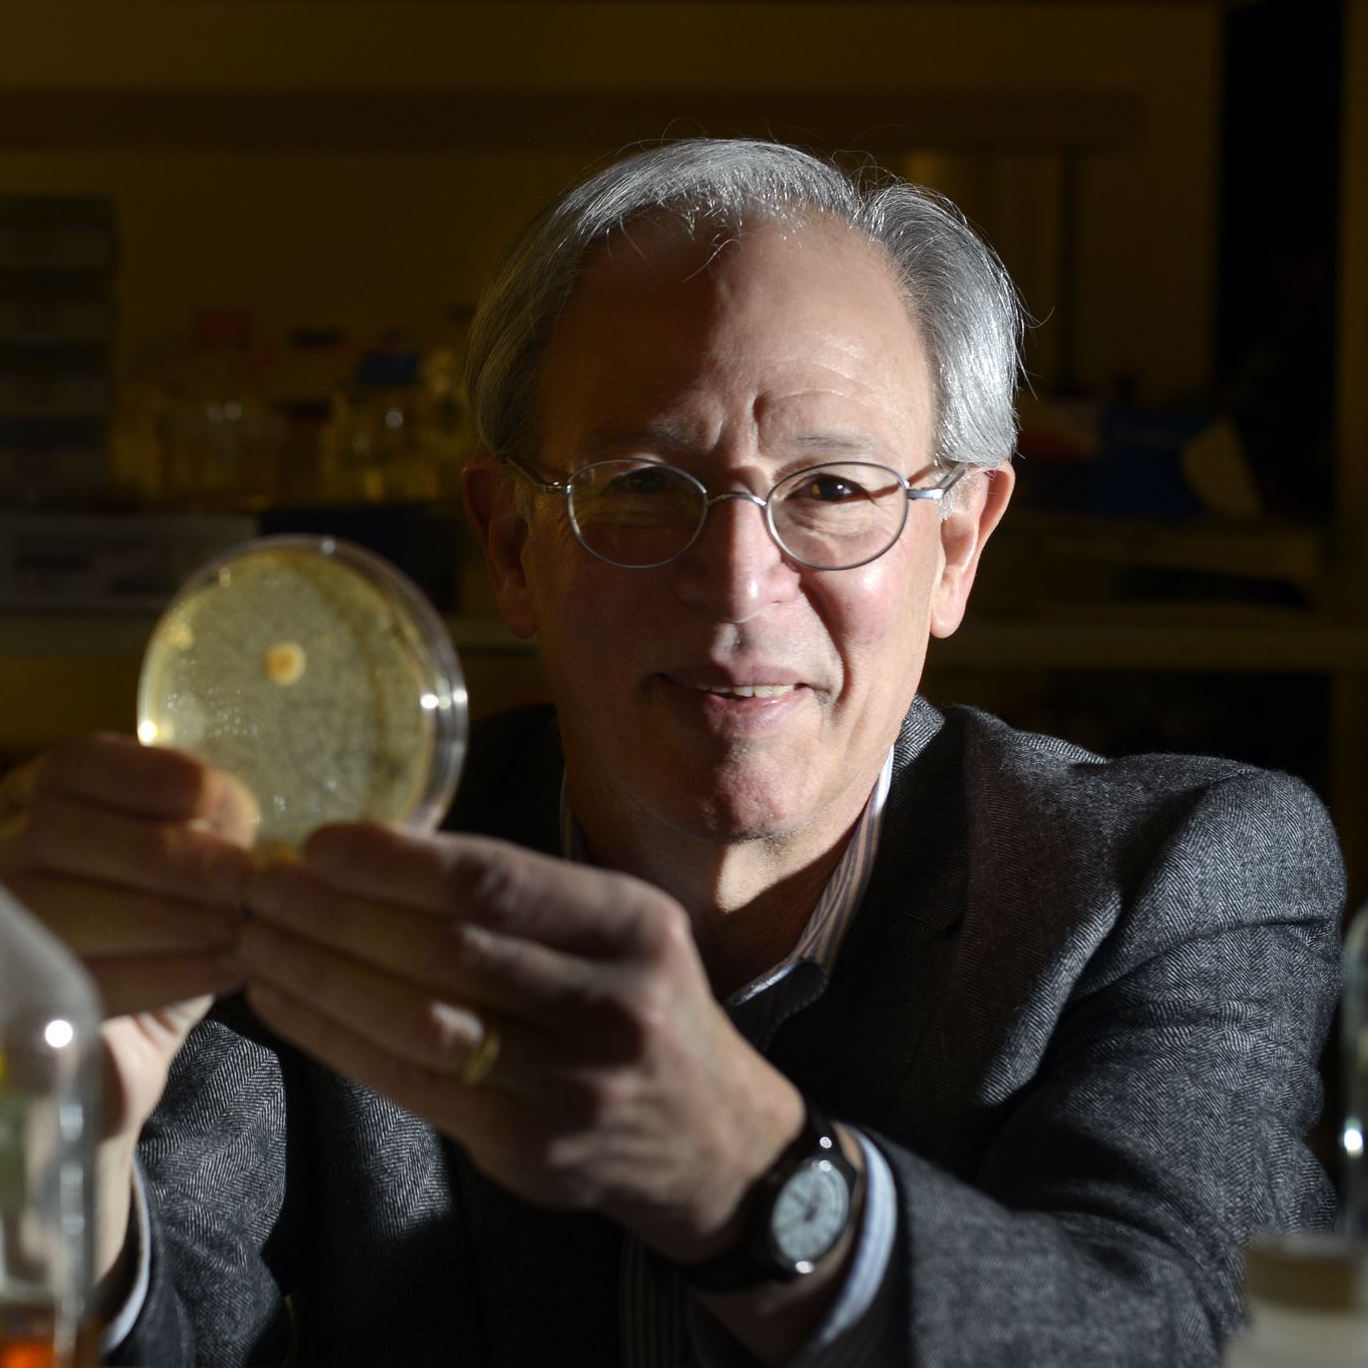
jon_jarvik.jpg

PRAISE FOR THE VANDEMONIAN
Richard Rowland is the owner of http://norlandrobotics.com

“Wow, what a great read! Yes, I had to look up the word Vandemonian: “a person from Tasmania”, but, as soon as I’d read the blurb, I was hooked! Many years after the 1980’s, I learned that Australia was way ahead of America as far as robotics were concerned. Much of the book is about Allan’s work all over the world with robot companies, plus so much more. Being a robot collector, my main interest was his time at General Electric Plastics, Commodore, Denning, and Flexible Systems (Tasman Turtle), among several others. What surprised me and expanded my knowledge was Allan’s life story. All the ups and downs, hardships and fame. It was so interesting – all the famous people he worked with! The theme of the book is to take his experience of a doomed robot industry and use those successes, mistakes, and failures to rescue other industries. So, if you want a little history on 1980’s robots, some great ideas on how to make a business succeed, or a story of success of someone else’s hard life, I recommend you get a copy. “
“Fascinating, quirky and in some ways an eye opener. I like the pace, the breadth, emotional depth. Find it hard to put down.”
Jacob Jonker, author and philosopher, Holland.

Terry Young grew up near Cincinnati, Ohio and became a journalist and feature writer for daily newspapers in Cincinnati, Dallas, and Los Angeles. He later went on to become a business executive in the financial services sector, where he created and led award-winning public relations, communications, and marketing efforts. Terry is now a writer, a hiker and explorer. A happy camper. He recently spent three weeks traveling around and meeting people in Tasmania. He is already planning a return trip.

“An interesting life can make for an interesting story—and Allan Branch proves it.
Engineer, inventor, problem-solver, turnaround specialist, and relentless optimist, Allan has pinballed his way through a remarkable life. Now, he’s paused long enough to share it in his book, The Vandemonian: Wall Street and Silicon Valley Collide.
A “Vandemonian” refers to a descendant of the explorers and convicts who settled Van Diemen’s Land—now known as Tasmania. It’s a fitting term for Allan, whose story is about growing up in the middle of nowhere but coming of age in the middle of everything.
Raised in small rural village in a remote part of the remote island of Tasmania, Allan parlayed his blend of curiosity and optimism into a noteworthy journey.
Along the way, he navigates everything from the boom years of business in Texas to the fast-moving and confident currents of Wall Street and Silicon Valley—punctuated by detours through dusty backroads, rough waters on the coast of Maine, and historic corners of Europe as he reveals the places and people who influenced his life, and became part of Allan’s interesting saga set at the front edge of the Tech Age.
At its core, this is a story of momentum—of saying “yes” and figuring things out along the way. Allan’s early work in robotics and “robot intelligence” was driven by a simple belief: Yes, I can. That mindset carried him from fixing gadgets onward to boardroom negotiations, showing both the power—and limits—of optimism.
But beneath the adventure lies something more personal. As Allan reflects, “While I was living that life of non-stop adventure… I was a lonely man. Always leaving somewhere, someone, going to somewhere, someone.”
Now that he has put his journey on pages, we can finally join him—not just through the places he’s been, but through the lessons he’s learned.”
“To the Randy, Intellectual Forrest Gump Vandemonian, I enjoyed reading your tomb immensely. (Even though it was quite technical.) I am a member of Resna – you would have been great designing adaptive devices for the disabled. What an exciting life you have led. I can’t wait to hear what you are up to next.”
Leslie Goldberg, New York.
“I can’t remember ever enjoying a read as I did your book. Your life and career adventures are amazing.”
Kerrell-ann Hack, Chairperson Devonfield Enterprises, Inc.
Your memoir, The Vandemonian: Wall Street and Silicon Valley Collide, presents a rare convergence of robotics innovation, corporate leadership, and international business strategy. The progression from Tasmania to global technology and financial centers combined with firsthand experience in smart mobile robotics and corporate turnarounds positions this work well within a readership that values entrepreneurial insight grounded in lived experience. With publication through Big Sky Publishing and distribution by Simon & Schuster, the foundation is already established for broader reader engagement.
Esther Tony, Good Reads Group
Karb Studio, Bangkok

Suthipong Suriya, known as Karb, is a multi-award winning food stylist and published author of several culinary books. In his amazing studio in Bangkok, he graciously added my memoir to his collection. Having just returned from winning six awards, this time the Gourmand Awards in Portugal, in return for a believe it or not take-out lunch, I treated his travel migraine with a Shiatsu massage.

20 December 2025, news that Kaub has just been awarded a commendaton from the Thai Royal Family for his community service contributions, creating a art and craft museum in his home town.

“Impressive. A lot of people born on this island end up doing remarkable things far from here. Allan Charles Branch is one such example. The Vandemonian is at once a memoir, travel and business lessons, from a man born in 1950 in the tiny Hydro village of Waddamana and who ended up in Silicon Valley. Readers interested in business memoirs will appreciate Branch’s insights on revitalising companies – from mining to robotics – and the lessons he learned along the way. What Branch does well is tell a decent yarn. Some of his descriptions of life in Waddamana and visits to Hobart in the 1960s will be familiar to many. If this book has a theme it is a Tasmanian’s journey through the diverse and confronting United States. Branch describes his life as like a “slalom with the odd ski jump and side trips to the piste with the inevitable catastrophes. This book reads that way.”

Gregory Barns SC, is a prominent human rights lawyer and author of “Rise of the Right,” “What’s Wrong with the Liberal Party?”, “Selling the Australian Government: Politics and Propaganda from Whitlam to Howard” and “Groundswell” in the prestigious Quarterly Review. Greg is a company director and widely published political commentator regularly appearing in major newspapers.
“I could not put it down.”
Glenny Clarke, coroner, veterinarian and entertainer.
“Just finished your book and was surprised to learn and admire your life history. I found it interesting and learnt about building a business. Your womanising was amusing to read in a book that may have been a boast or just there because of your loneliness for female company.” mile high”. You certainly have enjoyed life and made many companies very happy.” Jacquie Carrick Brownlow, author.
“I’m loving your book, it’s a fascinating read. You’ve inspired me to put together some of my stories…” Kim
“Thought I would touch base to let you know how much I am enjoying reading your book. I love just choosing a chapter and reading it without having to remember where I was up to as happens in most conventional books. I have found that it is very easy to read and sounds just the same as if you were talking to me.” Judy Richmond, printer-publisher, union leader, disability services volunteer.
“I have just finished your book – it’s a great read, thanks. Your great skill is in making things work and this, in turn, requires an intuitive grasp of ‘mechanism’ (of both robots and companies) I reckon you started off with an innate aptitude and honed it to perfection in your late teens working at the TV repair shop and the Ag. Dept. What a great education!” John Reid, author, CSIRO scientist (retired).
“I most certainly did read your book and thoroughly enjoyed it. I found the industry tales fascinating, I had no idea just how much you had accomplished (and that you could write so well). Not bad for a bloke from Tassie! Your family stories were heartfelt and I felt like I was there with you. Got Nick to read a couple of chapters about the old Hydro village as he works with Hydro now. The chapter on Dad was spot on. You captured him perfectly.” Liz.
“Your life story itself is interesting and worth sharing, Unique title, but who knows the meaning of ‘Vandemonian’? I prefer chronological, sometimes long winded, less is often better. Great corporate giants. Lots of names of companies and business people, except for the mention in the book, often not much else to connect with them. Reading about saving Kari, you dog, I am finally hooked, a real page turner. Nice to read your positive comments about my native country.” Jan-Willem, Holland.
“The typical founder biography is often about a solitary, highly competitive genius whose affluent parents support his entry into the best schools or even the best countries to work in. If the book is an autobiography, it tries to hide that the person is someone most of us wouldn’t enjoy having over for dinner. Allan’s story of life as a successful serial entrepreneur is very different, where a rural working-class background populated with real versions of the laid-back Aussie stereotype leads to business success and a life well-lived. The book intertwines humorous self-deprecating vignettes with the lessons learned from managing, starting, and turning around companies amid the drama of Hillbilly Elegy-like brushes with family dysfunction and mental illness. Indirectly it suggests that an answer to how to get more kids into STEM may not be to sign them up for yet another after-school class or robot competition, but instead provide love, tools, and plenty of time to explore and experiment. Be prepared to take notes, you’ll want to make a playlist of all the songs and musicians he loves- or, better yet, have him over for dinner and ask him yourself.”

Robotics scientist and practitioner Robin Murphy is Raytheon Professor, Computer Science & Engineering at Texas A&M University in College station, TX. With multiple awards and publications, Robin created the world famous Disaster Robotics project to effectively apply robots at times and locations of natural or man-made recovery incidents.
“I’m loving your book …. thoroughly enjoyed reading all of it …. Anyone who knows you would have the same experience I am sure. It is very much you Allan, with plenty of droll anecdotes that resonate.
What it would need to give it mass appeal is more of the dark side of events – the failings of you and of others. You were judicious and didn’t give details or back-story where it might make you or someone else look or feel bad. And that is good.”
Jonathan W. Jarvik is Associate Professor in the Department of Biological Sciences at Carnegie Mellon University in Pittsburgh PA. Jon pioneered gene tagging technology that aids in the analysis of protein synthesis and roles in molecular biology, and has known Allan and much of the adventure described in this memoire in detail, particularly the anecdote around Jon’s brother Robert Jarvik of artificial heart fame, so has insightful comments.
“Good stuff! I really enjoyed this version and was much moved by much of it.”
The story is entertaining, informative, and unsettling. Allan and I have crossed/almost crossed paths occasionally, but our backgrounds and general experience are so different that it’s surprising to find that we come to the same basic views on what’s good and important. The narrative is stuffed with stories about famous companies and people…some I have known, and some I didn’t know I knew, revealing a whole lot about how new technology actually comes into use. It isn’t an orderly process, and this isn’t an orderly book. It’s full of pain and emotion. It begins conventionally enough by recounting his stressful youth in a village in Tasmania, during which he learns that he’s smart, technically adept, and tough enough to protect himself and his siblings. His story moves on through oddly varied education and increasingly high level professional activity to his becoming a consultant, company-fixer, and constant round-the-world traveler…but that story isn’t chronologically straightforward. He keeps recalling, sometimes repetitiously, the many people who have been important to him, but the repetition is helpful, because who remembers all the names and relationships he’s talked about earlier? The book’s 280 pages are a picture to be viewed as a whole …kinda like a life. Good stuff.

Nels Winkless is a widely published commentator and writer of technology books, particularly robotics and AI. He is the author of “Robots On Your Doorstep”, “Excuse Me What Was That”, “Climate and the Affairs of Men”, “If I Had a Robot, What to Expect from the Personal Robot” and “A Different Take on Our Technical Times”. Nels was the first editor of Computing, the pioneering personal computer magazine. His global Correspo newsletter has been running now for 30 years.
“In this remarkable memoir, Allan invites readers on an unpredictable global journey …
Told through vivid vignettes – captures Allan’s journey of invention and transformation – revealing the man behind the robots. Blending the introspective depth of Paul Auster’s Winter Journal with the transformative arc of Frank McCourt’s Angela’s Ashes. A compelling narrative of human ingenuity and perseverence.
Big Sky Publishing
